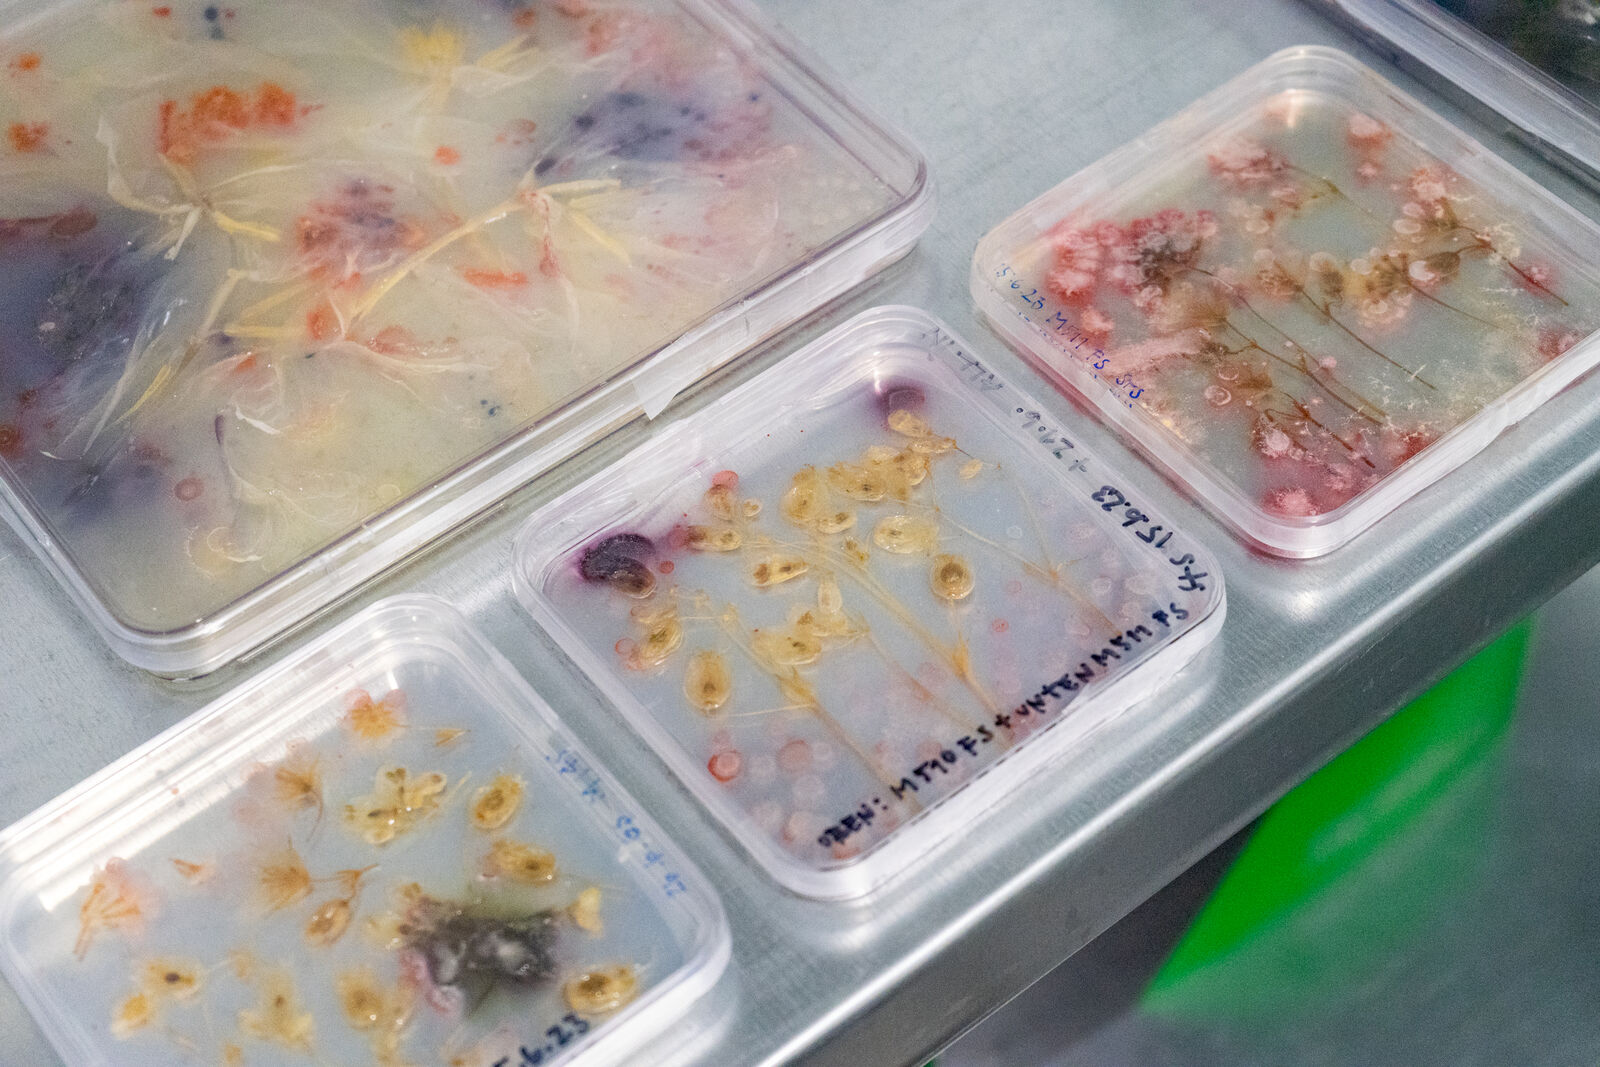
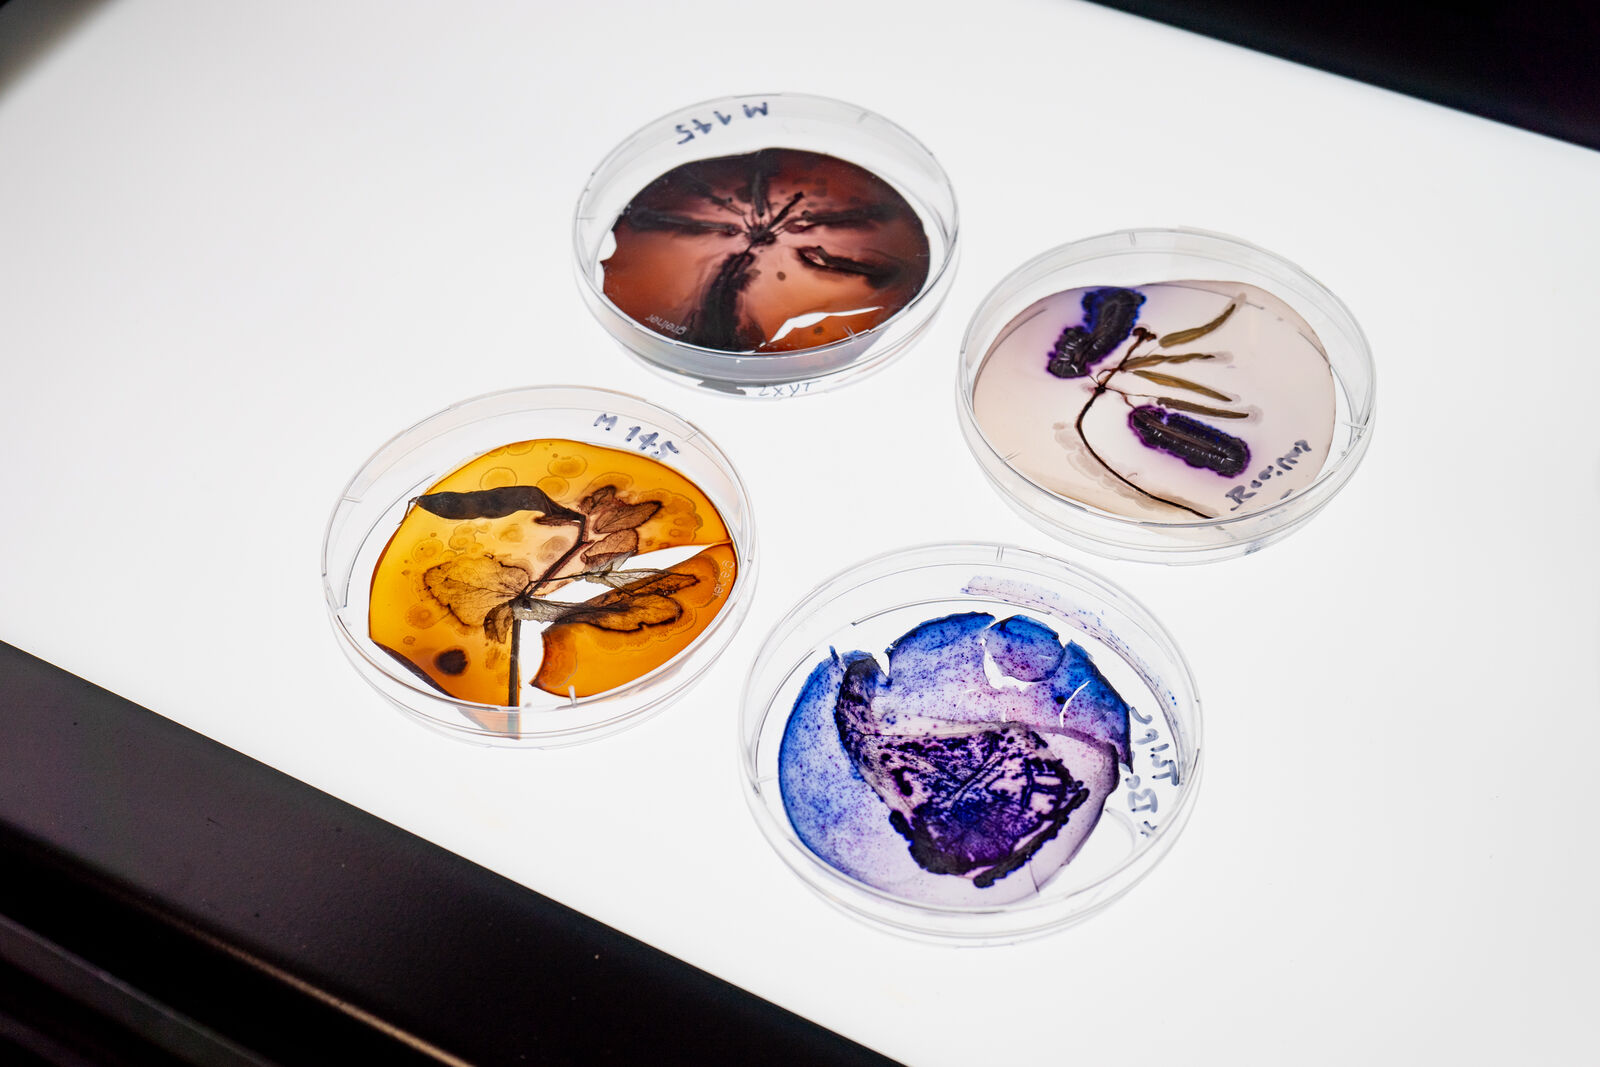

Microverse
Photographs Created by Kathrin Linkersdorff in Collaboration with Regine Hengge Exhibited at Deichtorhallen
Circularity and sustainability of material flows is a hallmark of intact ecosystems. This principle has now been stunningly visualized in ultrahigh resolution, large format photographs - the MICROVERSE series - created by Kathrin Linkersdorff in collaboration with Cluster member Regine Hengge, Professor for Microbiology at Humboldt-Universität zu Berlin. In the project, the soil bacterium Streptomyces coelicolor was allowed to meet, sense and grow on destained flowers and other decaying plant materials of exquisite microstructural beauty. In a re-enactment of what normally happens in dark soil, large-scale Petri dishes became the stages where the growing bacterial performers interweaved with filigree petals and leaves, fled or succumbed to deadly plant toxins, burst into the production of blue, red or orange-brown pigments with antibiotic activity to deter potential competitors, produced their dusty white survival spores, and occasionally were in turn killed and digested by hairy moulds. Ultimately, these organic cycles of growth and decay created growing images of translucent dead plants blossoming again under the spell of microbial pigments, thereby blending science and art in a living ›Theatrum naturae et artis‹.
The photographs will be shown for the first time in a solo exhibition of Kathrin Linkersdorff at PHOXXI entitled »Works«. The exhibition will be inaugurated on October 26th, 2023 at Deichtorhallen Hamburg and run until January 21st, 2024. For more information see the website of the exhibition site.
Deichtorhallen - Internationale Kunst und Fotografie Hamburg
Halle für aktuelle Kunst
Haus der Photographie
Deichtorstr. 1-2
20095 Hamburg